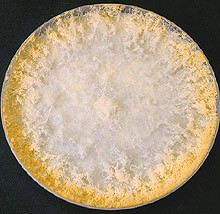

Biologie moléculaire et applications
LA BIOLOGIE MOLÉCULAIRE ET SES APPLICATIONS
Une nouvelle phase de la génétique s'ouvre, où l'on abandonnera progressivement les discussions sur l'existence des gènes, définis par leurs conséquences sur les traits, pour se concentrer principalement sur la détermination de la nature physico-chimique du gène, un effort qui se focalisera vite sur l'acide nucléique, l'ADN et sur son mode d'action.
Thèmes traités et activités pédagogiques (durée: 3 semaines):
![]() La convergence de la génétique et de la biochimie: le concept "un gène -> une enzyme"
La convergence de la génétique et de la biochimie: le concept "un gène -> une enzyme"
![]() Découvertes autour de l'ADN, support de l'information génétique
Découvertes autour de l'ADN, support de l'information génétique
![]() Découvertes des mécanismes de l'expression des gènes
Découvertes des mécanismes de l'expression des gènes
![]() Découverte des enzymes de restriction
Découverte des enzymes de restriction
![]() Le clonage et le séquençage des gènes
Le clonage et le séquençage des gènes
![]() La nouvelle conception du gène
La nouvelle conception du gène
1 La convergence de la génétique et de la biochimie: le concept "un gène -> une enzyme"
MORGAN n'a pas apporté de précision sur les mécanismes d'action des gènes, pourtant, dès le début du XXe siècle, des observations avaient suggéré un lien existant entre les gènes et les réactions chimiques du métabolisme.
1.1 LES TRAVAUX DE GARROD (1902)
La première relation entre un gène et une enzyme est établie en 1902 par Archibald GARROD à Londres au St Bartholomew's Hospital, en observant un jeune garçon atteint d'alcaptonurie.
Après la naissance dans la même famille d'un autre enfant atteint d'alcaptonurie, Garrod se rend compte que les deux parents sont cousins germains. Il étudie les autres cas d'enfants alcaptonuriques et observe que la transmission de cette anomalie s'effectue chez l'homme selon les lois de Mendel: mode autosomal récessif, ce qui lui laisse penser qu'elle est due à un gène unique. Il suggère donc que la déficience enzymatique soit due à une anomalie du gène responsable de la synthèse de cette enzyme.
GARROD publie ces observations en 1909 dans Les erreurs innées du métabolisme, où il avance une explication similaire pour plusieurs maladies génétiques (albinisme, cystinurie, pentosurie). Dans le cas présent, il écrit: "l'ouverture du cycle benzénique [de la molécule de tyrosine] est dans le métabolisme normal, le travail d'une enzyme spéciale et cette enzyme est absente dans l'alcaptonurie congénitale."
1.2 LES EXPERIENCES DE BEADLE ET TATUM SUR NEUROSPORA
Les remarquables conclusions de GARROD ne pouvaient aboutir à un programme de recherche, car des défauts génétiques décrits chez l'homme ne pouvaient pas se prêter à des expériences génétiques.
George BEADLE, en compagnie de Boris EPHRUSSI, choisit tout d'abord l'organisme modèle "drosophile", sur lequel ils étudient la coloration des yeux . La synthèse des pigments responsables de cette coloration représenterait le résultat d'une chaîne de réactions dont chaque étape est contrôlée par une enzyme, chacune de ces enzymes étant elle-même le produit de l'activité d'un gène. Mais la complexité du système ne permet pas d'établir une conclusion définitive.
BEADLE se tourne alors vers un système biochimique plus simple, décrit dans l'organisme modèle Neurospora crassa, un champignon haploïde. Avec Edward TATUM, qui avait une bonne expérience de la culture de ce micro-organisme, il mène des travaux à l'université de Stanford pendant la deuxième guerre mondiale et les publient en 1941. En 1946, BEADLE prend la succession de MORGAN au CalTech (California Institute of Technology).
1.2.1 Cultures de Neurospora
Neurospora crassa est une moisissure cultivable sur un milieu artificiel qui ne contient que du sucre, des sels minéraux, et de la biotine (vitamine du groupe B appelée aussi vitamine H). Par irradiation, BEADLE et TATUM obtiennent des mutants incapables de se développer sur ce milieu minimal (MM), mais qui poussent sur un milieu complémenté avec tel ou tel métabolite.
En particulier, des mutants de phénotype [Arg-], auxotrophes (=qui nécessitent la présence d'un nutriment) pour l'arginine sont cultivés. On précise la chaîne de biosynthèse de l'arginine:

Trois souches [Arg-] sont cultivées sur milieu minimum (MM) et sur des milieux supplémentés en une ou plusieurs substances de la chaîne de biosynthèse de l'arginine.
Les résultats obtenus sont traduits ci-dessous (+ : croissance, - : pas de croissance):

![]()
![]() En vous inspirant de la conclusion de GARROD vis-à-vis de l'alcaptonurie, essayez d'expliquer la cause de chacune des mutations ci-dessus: un schéma est souhaité.
En vous inspirant de la conclusion de GARROD vis-à-vis de l'alcaptonurie, essayez d'expliquer la cause de chacune des mutations ci-dessus: un schéma est souhaité.
1.2.2 Cultures de dicaryons de Neurospora
 La mise en contact de deux filaments haploïdes de Neurospora permet d'obtenir des "dicaryons" fonctionnant comme des cellules diploïdes.
La mise en contact de deux filaments haploïdes de Neurospora permet d'obtenir des "dicaryons" fonctionnant comme des cellules diploïdes.
Des expériences de fusion ont donné les résultats ci-dessous quant à la capacité des dicaryons de croître sur milieu minimum:
![]()
![]() Expliquez les potentialités biochimiques des différents dicaryons en exprimant leur génotype que vous schématiserez en en faisant une représentation chromosomique.
Expliquez les potentialités biochimiques des différents dicaryons en exprimant leur génotype que vous schématiserez en en faisant une représentation chromosomique.
Ces études montrent que chacun des mutants est en réalité déficient en une des enzymes nécessaires à l'une des étapes de la chaîne métabolique. L'analyse génétique de ces mutants permet à BEADLE et TATUM de montrer que chacune des déficiences segrège de façon mendélienne, et correspond donc à une mutation dans un unique gène. L'ensemble de ces observations aboutit donc à la conclusion que les gènes contrôlent la synthèse des enzymes, et que chaque protéine est codée par un gène différent. Ceci conduit BEADLE et TATUM à exprimer la relation entre la présence d'un gène et la synthèse d'une enzyme ce que Norman HOROWITZ traduisit en 1948 par le célèbre aphorisme : "un gène -> une enzyme", généralisé par la suite en "un gène -> un polypeptide".
Ces travaux concrétisent ainsi la rencontre de la biochimie et de la génétique : la protéine vient combler la lacune qui existait entre le gène et le caractère. BEADLE et TATUM se verront récompensés en 1958 par l'attribution du prix Nobel de physiologie et de médecine.
2 Découvertes autour de l'ADN, support de l'information génétique
 2.2.1 Préliminaire:
2.2.1 Préliminaire:
Les pneumocoques sont des bactéries responsables d'une pneumonie chez les Mammifères.
Il en existe deux formes: les pneumocoques de type R et les pneumocoques de type S qui se distinguent l'une de l'autre par la morphologie de leurs colonies et celle de leurs cellules comme le montre la figure ci-contre.
2.2.2 Les expériences proprement dites:
En 1928, le biologiste anglais GRIFFITH suspecte la possibilité de transformation de bactéries.
Il réalise l'expérience ci-dessous.

![]()
![]() Vous interpréterez le sort des souris des quatre lots.
Vous interpréterez le sort des souris des quatre lots.
Ce n'est qu'en 1944, après dix années de recherches que le principe transformant est identifié par Oswald AVERY, MAC LEOD et MAC CARTHY qui publient dans le Journal of Experimental Medicine:
" [...] la fraction active consiste principalement, sinon uniquement, en une forme visqueuse, hautement polymérisée d'acide désoxyribonucléique".
Le facteur transformant susceptible d'être intégré par d'autres bactéries leur confère de façon héréditaire de nouvelles propriétés génétiques.
La découverte d'AVERY a été accueillie avec beaucoup de scepticisme et la reconnaissance de l'ADN comme le support chimique de l'hérédité aura du mal à s'imposer.
2.3 LES TRAVAUX DE ERWIN CHARGAFF (1950):
Quand il prend connaissance des travaux d'AVERY, CHARGAFF comprend que l'ADN occupe une place centrale dans les mécanismes héréditaires et il décide de consacrer les activités de son laboratoire de biochimie à l'Université de Columbia à l'étude des acides nucléiques.
En 1950, grâce aux progrès de la chromatographie sur papier, il publie ses travaux sur le contenu en bases azotées de l'ADN chez diverses espèces.
|
COMPOSITIONS NUCLEOTIDIQUES (%) | ||||
|
Organismes |
A |
T |
G |
C |
|
Homme |
30,9 |
29,4 |
19,9 |
19,8 |
|
Poulet |
28,8 |
29,2 |
20,5 |
21,5 |
|
Sauterelle |
29,3 |
29,3 |
20,5 |
20,7 |
|
Oursin |
32,8 |
32,1 |
17,7 |
17,3 |
|
Blé |
27,3 |
27,1 |
22,7 |
22,8 |
|
Levure |
31,3 |
32,9 |
18,7 |
17,1 |
|
E. coli |
24,7 |
23,6 |
26,0 |
25,7 |
|
Methanococcus |
34,5 |
34,2 |
15,9 |
15,5 |
![]()
![]() Analysez les rapports A+T / C+G et C / G ou A / T selon les espèces. D'après les connaissances sur l'ADN que vous avez de la classe de 2e, pouvez-vous expliquer ces constatations?
Analysez les rapports A+T / C+G et C / G ou A / T selon les espèces. D'après les connaissances sur l'ADN que vous avez de la classe de 2e, pouvez-vous expliquer ces constatations?
L'ADN est donc porteur d'une certaine spécificité: cette molécule n'a pas une structure polymérique monotone, elle est donc susceptible de contenir une information. Les travaux de CHARGAFF vont contribuer à répandre l'idée que l'ADN puisse être une molécule porteuse de l'information génétique.
Ses observations seront déterminantes pour l'élaboration du modèle de la structure de l'ADN par WATSON et CRICK quelques années plus tard.
2.4 LES TRAVAUX DE WATSON ET CRICK (1952):
Il faut comprendre l'influence des physiciens au milieu du XXe siècle pour prendre la mesure des orientations que prend la biologie dans le domaine moléculaire et à ce sujet une lecture du paragraphe 5 de l'article de Alain BERNOT et Olivier ALIBERT du Génoscope (Groupement d'Intérêt Public) s'avère intéressante.
James Dewey WATSON a décrit dans un livre passionnant "La double hélice" (1968) le récit de la formidable découverte qu'il a réalisée avec Francis CRICK.
Alors qu'ils s'apprêtent à mener leurs travaux, les deux chercheurs disposent des éléments suivants :
o la composition chimique de l'ADN (désoxyribose, bases azotées A, T, C, G et acide phosphorique);
o les clichés de diffraction aux rayons X d'ADN cristallisé, dus principalement à Rosalind FRANKLIN et Maurice WILKINS du King's College. Ces clichés montrent une figure en croix, caractéristique des structures en hélice .
o les travaux de Erwin CHARGAFF, qui avaient montré que pour toute molécule d'ADN, le nombre de molécules d'adénine est égal au nombre de molécules de thymine, et que celui de cytosine est égal à celui de guanine ;
o les analyses en microscopie électronique, qui avaient montré que le diamètre de la molécule d'ADN est de 20 Å, ce qui suggérait que cette molécule comportait deux chaînes de désoxyribose-phosphate.
Ils proposent en fin de compte un modèle de structure de la molécule d'ADN qui recevra l'assentiment de toute la communauté scientifique et recevront avec M.WILKINS le prix Nobel de médecine en 1962.
2.5 LA DECOUVERTE DU MODE DE REPLICATION DE L'ADN

Un des articles publié par WATSON et CRICK en 1953 mentionnaient: "il n'a pas échappé à notre attention que l'appariement spécifique des bases que nous avons postulé, suggère immédiatement un mécanisme de réplication de l'ADN."
En d'autres termes, ils s'étaient bien rendu compte que, une fois la structure de l'ADN déchiffrée, le mystère de la réplication (ou de la duplication) de l'ADN serait bientôt élucidé. La nature semi-conservative du processus de réplication de l'ADN fut proposée par eux sur des bases purement théoriques.
Matthew MESELSON et Franklin STAHL en firent la première démonstration pratique en 1958, en utilisant la Bactérie intestinale Escherichia coli. Une démonstration de la réplication semi-conservative très semblable fut menée par James Herbert TAYLOR, en utilisant des chromosomes de fève (voir le programme de 1èreS).
3 Découverte des mécanismes de transcription des gènes
3.1 VISION ACTUELLE DE LA BIOLOGIE MOLECULAIRE
3.2 LES DECOUVERTES DE L'ARN MESSAGER ET DU CODE GENETIQUE:
A la fin des années 1950, on sait que les gènes codent pour l'assemblage ordonné des acides aminés d'une protéine synthétisée au niveau des ribosomes cytoplasmiques. Mais point d'ADN sur les ribosomes: on envisage qu'une autre molécule servant de matrice, porte l'information de l'ADN aux ribosomes.
On pense à l'ARN ribosomial: les ribosomes sont des grains, découverts par Georges PALADE, associés ou non à des membranes (ergastoplasme ou REG = reticulum endoplasmique granuleux) et impliqués dans l'assemblage des acides aminés. Ils furent longtemps appelés grains de Palade.
3.2.1 VOLKIN-ASTRACHAN et leur "curieux"ARN :
En 1956, Elliot VOLKIN et Lazarre ASTRACHAN ont effectué l'expérience suivante :
Culture d'E. coli,
Infection de la culture avec le bactériophage T2,
Marquage au 32Pi quelques minutes immédiatement après l'infection,
Isolement et analyse de l'ARN marqué.
Leur analyse a indiqué que l'ARN marqué isolé a représenté seulement 2% de tout l'ARN dans la cellule et il était labile. En outre, la composition en bases de l'ARN fut une surprise:
|
Composition en bases | ||||
|
|
ADN du phage |
ARN marqué |
ADN d'E. coli |
ARN d'E. coli |
|
A |
32 |
33 |
25 |
26 |
|
U ou T |
32 |
29 |
25 |
19 |
|
C |
18 |
20 |
25 |
25 |
|
G |
17 |
18 |
25 |
19 |
![]()
![]() Montrez en quoi cette composition était inattendue. Sauriez-vous expliquer cet état de fait avec les connaissances actuelles?
Montrez en quoi cette composition était inattendue. Sauriez-vous expliquer cet état de fait avec les connaissances actuelles?
La pleine signification de ce résultat n'a pas été appréciée pendant un certain nombre d'années.
3.2.2 La découverte de l'ARN messager et le décryptage du code génétique:
Une nouvelle idée émerge, qui invalide le rôle de l'ARN ribosomial comme intermédiaire: c'est celle de François JACOB, Jacques MONOD et André LWOFF, tous trois travaillant à l'Institut Pasteur.
"MONOD avança alors l'idée, conçue par F. JACOB et lui, qu'existait peut-être un ARN, jusque là non décrit [...]. Il le baptisa messager pour rendre compte du fait qu'il devait s'agir d'une molécule fabriquée à partir de gènes, sans doute transportée au niveau des ribosomes [...]. une telle hypothèse était à l'époque hardie: elle revenait à dire que l'ARN ribosomial n'avait aucun rôle direct dans le transfert de l'information." F. GROS - Les secrets du gène.

Plusieurs équipes présenteront des protocoles expérimentaux différents, qui conduiront tous à admettre l'existence d'un ARN messager qui s'associe temporairement à l'ARN ribosomial pour assurer la synthèse protéique (voir le cours de 1ère S: transcription et traduction).
Il reviendra à Marshall Warren NIRENBERG et J.Heinrich MATTHAEI en 1961 de mettre en évidence la réalité du code génétique qui sera entièrement décrypté en 1965.



